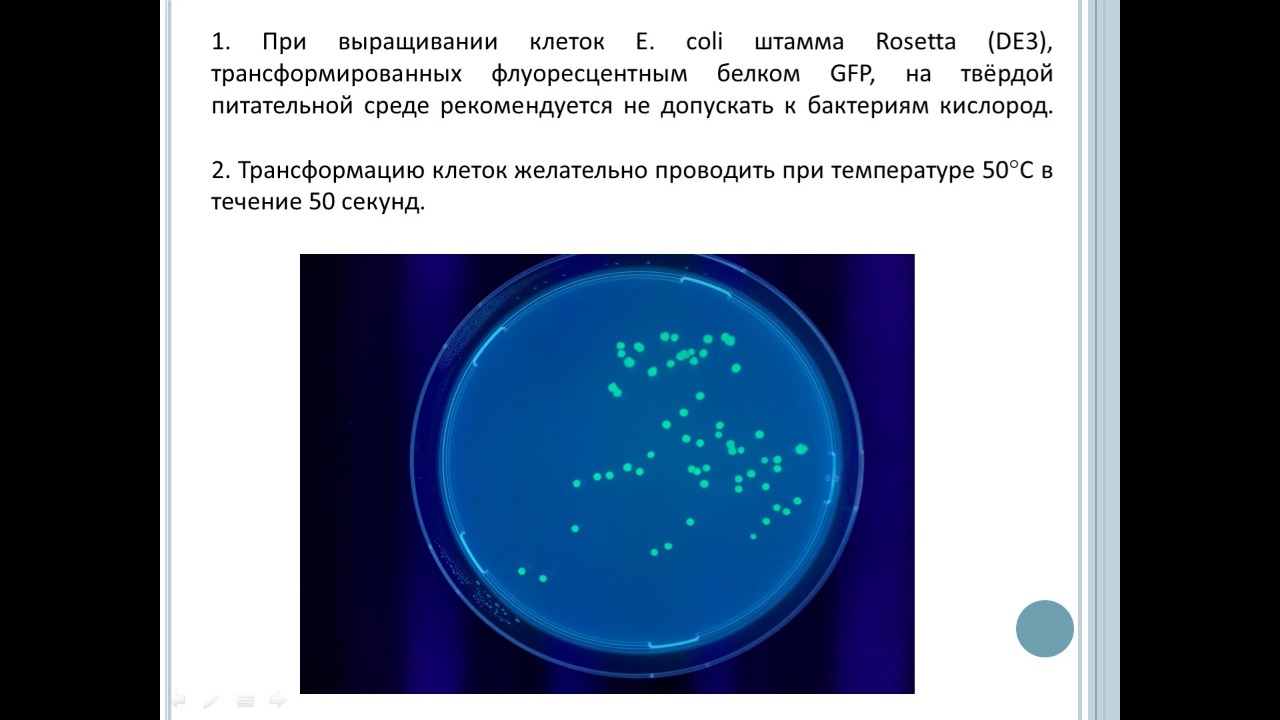
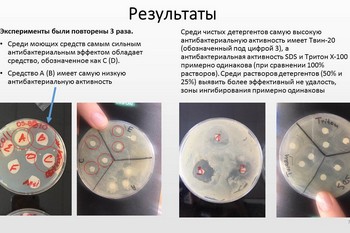

СТАРТ В МЕДИЦИНУ #медицинскийклассвмосковскойшколе 08.04.2020
Диапазон выбранных ими тем весьма широкий.

Гусейнова Эсмер.
"Влияние температуры и анаэробных условий на эффективность трансформации Esherichia coli ". Гусейнова Эсмер. В своей работе Эсмер показала, что изменений условий стандартной методики трансформации E.coli не только не ухудшает, а значительно улучшает эффективность трансформации. Увеличение температуры, а также создание анаэробных условий, значительно увеличивало количество исследуемых колоний.

"История о живых клетках и организмах, о процессах, лежащих в основе их жизнедеятельности. Введение в биохимию." Владыченская Елизавета Александровна. Работа посвящена разработке нового адаптированного курса по биохимии для учеников 10-11 классов. В ходе данного курса учащиеся должны получить общее представление о процессах, происходящих в организме человека, об основных химических циклах и реакциях.

Подготовка обучающихся медицинских классов к выступлениям на конференции Старт в медицину проходила в дистанционном формате. В этом году представляем свои работы по микробиологии, биотехнологии, биоинформатике, химии, истории медицины, гигиене и профилактике, а так же в секции для педагогов.
Удачи всем участникам!